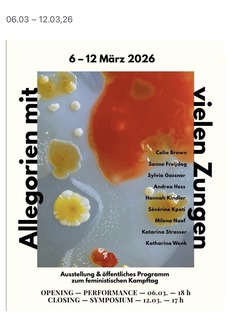
Allegorien mit vielen Zungen - Freiburg - 12.03.2026 17:00

Kunst
Allegorien mit vielen Zungen
- Wann
- Do, 12. März 2026, 17:00 Uhr
- Wo oder WAS
-
Freiburg
Schopf2 Kreativpioniere
Ausstellung & öffentliches Programm
zum feministischen Kampftag OPENING - PERFORMANCE - 06.03. - 18 h
CLOSING - SYMPOSIUM - 12.03. - 17 h
Celia Brown
Sanne Freijdag
Sylvia Gassner
Andrea Hess
Hannah Kindler
Sévérine Kpoti
Milena Naef
Katarina Strasser
Katharina Wenk
Quelle: Veranstalter
zum feministischen Kampftag OPENING - PERFORMANCE - 06.03. - 18 h
CLOSING - SYMPOSIUM - 12.03. - 17 h
Celia Brown
Sanne Freijdag
Sylvia Gassner
Andrea Hess
Hannah Kindler
Sévérine Kpoti
Milena Naef
Katarina Strasser
Katharina Wenk
Quelle: Veranstalter
Veröffentlicht am So, 22. Februar 2026 um 10:06 Uhr
- Schopfheimer Straße 2
- 79115 Freiburg im Breisgau
- Tel.: 0160 99149392
- Webseite
Wir brauchen Ihr Einverständnis für Google Maps!
Unter Umständen sammelt Google Maps personenbezogene Daten für eigene Zwecke und verarbeitet diese in einem Land mit nach EU-Standards nicht ausreichenden Datenschutzniveau.
Durch Klick auf "Akzeptieren" geben Sie Ihre Einwilligung für die Datenübermittlung, die Sie jederzeit über Cookie-Einstellungen widerrufen können.